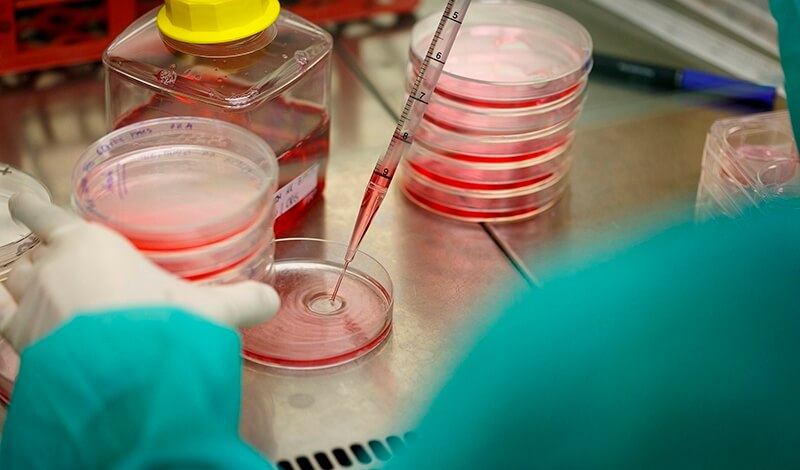

En compliment del REGLAMENT (UE) 2016/679 DEL PARLAMENT EUROPEU I DEL CONSELL de 27 d’Abril de 2016, relatiu a la protecció de les persones físiques pel que fa al tractament de dades personals i a la lliure circulació d’aquestes dades i a Llei Orgànica 3/2018, de 5 de desembre, de Protecció de Dades Personals i garantia dels drets digitals, l’informem que les dades personals proporcionades per vostè a través del lloc web https://www.pcb.ub.edu/intranet/ (d’ara endavant intranet), seran tractades en els següents termes:
1 – Responsable del tractament
Les dades personals recollides a través d’aquest lloc web seran tractades per FUNDACIÓ PARC CIENTÍFIC DE BARCELONA, amb domicili per a l’exercici de drets a c/ Baldiri i Reixac, 10-12 – 08028 Barcelona. E-mail: info@pcb.ub.cat.
Dades de contacte del delegat de protecció de dades: c/ Santiago Rusiñol 8 L.11, 08750, Molins de Rei – dpo@pcb.ub.cat.
2 – Finalitats del tractament
Aquesta intranet està pensada per a facilitar l’accés a tots els nostres serveis a totes les entitats i persones que formen part de la nostra comunitat. Per a això, s’han disposat tota una sèrie de formularis amb finalitats molt variades i amb tractaments de dades que quedaran definits de la següent manera:
2.1. Des de l´àrea de comunicació de PCB es gestiona la nostra Newsletter “t’interessa” on fem arribar a la comunitat de PCB les últimes novetats i notícies relacionades amb el parc i altres temes de l´àmbit de la ciència i la recerca. Per gestionar les sol·licituds de registre al butlletí, fem servir un breu formulari a la nostra intranet.
- El tractament de les dades recollides a aquest formulari es farà sota els següents termes:
- Legitimitat: El consentiment exprés de l’interessat manifestat mitjançant l’emplenament del formulari i l´interès legítim del responsable.
- Destinataris de les dades: Aquestes dades no seran cedides a tercers excepte per obligació legal.
- Duració del tractament: Les dades seran tractades mentre l´interessat no retiri el seu consentiment. Recomanem consultar l´apartat de drets per veure els diferents mitjans que posem a disposició dels usuaris per fer-nos arribar les seves sol·licituds.
2.2. Els membres de la nostra comunitat poden fer-nos arribar les seves queixes i suggeriments, així com també ens poden informar sobre qualsevol incidència que es produeixi als espais comuns del PCB, mitjançant la utilització dels diferents formularis que els posem a disposició.
El tractament de les dades recollides a aquest formulari es farà sota els següents termes:
- Legitimitat: L´interès legítim del responsable.
- Destinataris de les dades: Aquestes dades no seran cedides a tercers excepte per obligació legal.
- Duració del tractament: Aquestes dades seran tractades mentre siguin necessàries d’acord amb la seva finalitat i mentre es puguin derivar responsabilitats d´aquest tractament.
2.3. PCB disposa de taquilles individuals per a aquells que les sol·licitin a través del formulari habilitat a la nostra intranet. Aquestes sol·licituds són gestionades des del servei de recepció.
El tractament de les dades recollides a aquest formulari es farà sota els següents termes:
- Legitimitat: El compliment d’un contracte en el qual l’interessat és part o l’aplicació de mesures precontractuals a petició d’aquest.
- Destinataris de les dades: Aquestes dades no seran cedides a tercers excepte per obligació legal.
- Duració del tractament: Aquestes dades seran tractades mentre siguin necessàries d’acord amb la seva finalitat i mentre es puguin derivar responsabilitats d´aquest tractament.
2.4. Per a obtenir l’autorització necessària per a la captació d’imatges dins dels les nostres instal·lacions, serà necessari que empleni el corresponent formulari habilitat en l’àrea de «espais» de la nostra intranet. Aquesta sol·licitud serà revisada pel departament de comunicació de PCB.
El tractament de les dades per aquestes finalitats es farà sota els següents termes:
- Legitimitat: L´interès legítim del responsable.
- Destinataris de les dades: Aquestes dades no seran cedides a tercers excepte per obligació legal.
- Duració del tractament: Aquestes dades seran tractades mentre siguin necessàries d’acord amb la seva finalitat i mentre es puguin derivar responsabilitats d´aquest tractament.
2.5. Des del servei de recepció de PCB es gestiona el control d’accés a les instal·lacions, com a part dels serveis prestats a les entitats allotjades al parc. Abans de l’accés al recinte, serà necessari la identificació de les persones que vulguin accedir a les nostres instal·lacions. És per això que PCB habilitarà diversos formularis en la nostra intranet on els membres de la nostra comunitat, amb l’aprovació prèvia del responsable de l’entitat en la qual desenvolupi la seva activitat, podran cursar les següents sol·licituds:
- Demanar targeta identificativa per a nous usuaris
- Donar de baixa a un usuari
- Demanar un duplicat de la targeta identificativa
Sol·licitud accés puntual al PCB
El tractament de les dades per aquestes finalitats es farà sota els següents termes:
- Legitimitat: En compliment del nostre contracte de lloguer d´espais amb l´entitat sol·licitant i l´interès legítim del responsable.
- Destinataris de les dades: Aquestes dades únicament seran tractades per nosaltres o pels nostres encarregats del tractament a qui podem encomanar part dels serveis implicats, i només seran cedides a tercers en cas d´obligació legal.
- Conservació de les dades: Aquestes dades seran tractades mentre siguin necessàries d’acord amb la seva finalitat. Les dades personals dels visitants eventuals, una vegada transcorreguts 30 dies després de la seva visita, seran eliminades dels nostres sistemes.
2.6. PCB disposa de sales de reunions, auditoris i sales polivalents per a actes de networking, seminaris, workshops i congressos, entre d’altres. Pot gestionar les sol·licituds de reserva d’aquestes sales a través de l´eina habilitada per a aquesta finalitat a la nostra intranet, on també podrà consultar la disponibilitat d´aquestes sales.
El tractament de les dades recollides a aquest espai es farà sota els següents termes:
- Legitimitat: El compliment d’un contracte en el qual l’interessat és part o l’aplicació de mesures precontractuals a petició d’aquest.
- Destinataris de les dades: Aquestes dades no seran cedides a tercers excepte per obligació legal.
- Duració del tractament: Aquestes dades seran tractades mentre siguin necessàries d’acord amb la seva finalitat i mentre es puguin derivar responsabilitats d´aquest tractament.
2.7. Les entitats instal·lades al parc poden sol·licitar serveis de manteniment per assegurar el bon estat de les instal·lacions, així com també poden sol·licitar canvis a les instal·lacions per adaptar els espais que ocupen a la seva activitat. Aquestes sol·licituds poden gestionar-se mitjançant la utilització dels formularis corresponents gestionats per l´àrea de clients de la nostra entitat, i que trobarà a la intranet.
El tractament de les dades per aquestes finalitats es farà sota els següents termes:
- Legitimitat: En compliment del nostre contracte de lloguer d´espais amb l´entitat sol·licitant.
- Destinataris de les dades: Les seves dades podrien ser cedides a les empreses encarregades de realitzar aquest manteniment o reparació, per a facilitar la gestió de contacte entre les parts.
- Conservació de les dades: Aquestes dades seran tractades mentre siguin necessàries d’acord amb la seva finalitat i mentre es puguin derivar responsabilitats d´aquest tractament.
2.8. En aquesta intranet també es poden gestionar altes, baixes o sol·licituds d’accés puntual a serveis científics com ara instal·lacions radioactives, sales de reaccions especials, sales de cultiu, accés als serveis i instal·lacions del estabulari, i també fer sol·licituds de recollida d’aparells amb certificació de desinfecció per a l’eliminació d’equips.
El tractament de les dades per aquestes finalitats es farà sota els següents termes:
- Legitimitat: En compliment del nostre contracte de lloguer d´espais amb l´entitat sol·licitant i l´interès legítim del responsable.
- Destinataris de les dades: Aquestes dades únicament seran tractades per nosaltres o pels nostres encarregats del tractament a qui podem encomanar part dels serveis implicats, i només seran cedides a tercers en cas d´obligació legal.
- Conservació de les dades: Aquestes dades seran tractades mentre siguin necessàries d’acord amb la seva finalitat i mentre es puguin derivar responsabilitats d´aquest tractament.
2.9. Quan a través dels corresponents formularis ens sol·licita
- Una targeta per a utilitzar les fotocopiadores situades en els espais comuns del PCB.
- Donar-se d’alta en l’aplicació per a accedir al servei de gel sec.
- Poder disposar de fonts d’aigua en els seus espais privats.
- La utilització dels serveis de lloguer de roba i bugaderia
- Material de la nostra botiga
El tractament de les dades es farà sota els següents termes:
- Legitimitat: El compliment d’un contracte en el qual l’interessat és part o l’aplicació de mesures precontractuals a petició d’aquest.
- Destinataris de les dades: Aquestes dades no seran cedides a tercers excepte per obligació legal.
- Duració del tractament: Aquestes dades seran tractades mentre siguin necessàries d’acord amb la seva finalitat i mentre es puguin derivar responsabilitats d´aquest tractament.
3 – Exercici de drets
Pot exercir els drets d’accés, rectificació, supressió i portabilitat de les seves dades, de limitació i oposició al seu tractament, mitjançant escrit adreçat a Parc Científic de Barcelona al C/ Baldiri i Reixac, 10-12 – 08028 Barcelona. E-mail: info@pcb.ub.cat, com també pot posar-se en contacte amb el nostre DPO a l´adreça dpo@pcb.ub.cat. Pot demanar-nos en qualsevol de les direccions facilitades en aquesta política de privacitat, el nostre formulari de sol·licitud per a l’exercici de drets.
En cas de disconformitat amb el tractament, també té dret a presentar una reclamació davant l´autoritat de control (https://apdcat.gencat.cat).